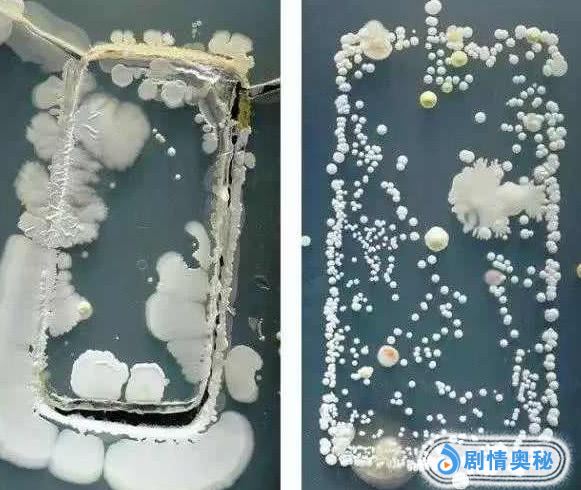
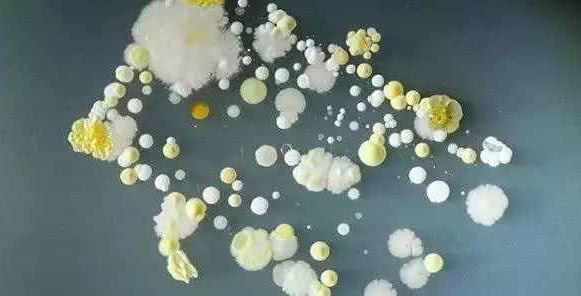
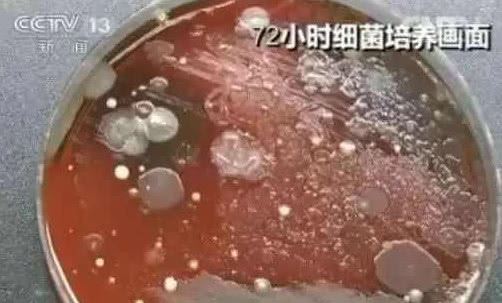
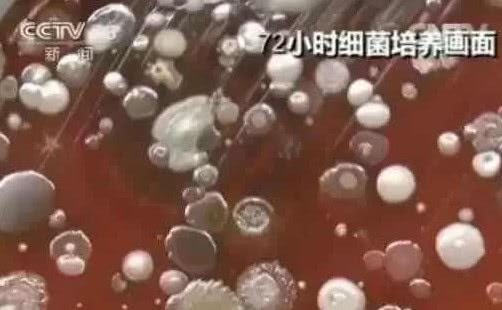

不知道大家在生活中有没有考虑过,一直近距离的接触自己的手机有多脏?其实这个也是之前央视提出的一个问题,在之后瞬间就引起了网友的关注,并且有很多网友直言,自己的手机也是会用酒精擦拭,看上去也是干净无比

但是真的是这样吗?在随手拿过一个手机放在显微镜之下也是可以很清晰的看见,在镜头之下,手机的一小块就有了数不清的细菌,并且还有很多的种类,这个也是让人直接看呆,甚至于有些网友还是不敢相信

在这之后也有测试是像网友说的那样,用酒精擦拭过手机之后才放在显微镜之下,但是这样做的效果可以说是几乎没用,细菌还是照旧的多,要知道手机是现在生活中最不能缺少的一样东西了,即便是上厕所的时候也是有人带着的

但是我们上厕所出来后,都会习惯的洗一下手,不知道有多少人会顺便洗手机呢?洗完手再次拿上手机,细菌再次回到手上,更不要说那些吃放都是抱着手机的人了,手指在屏幕上滑动一下,下一秒又拿着食物在吃,这样的来回也是最容易受到感染的时候,看完后你还敢抱着手机吃饭吗?


















